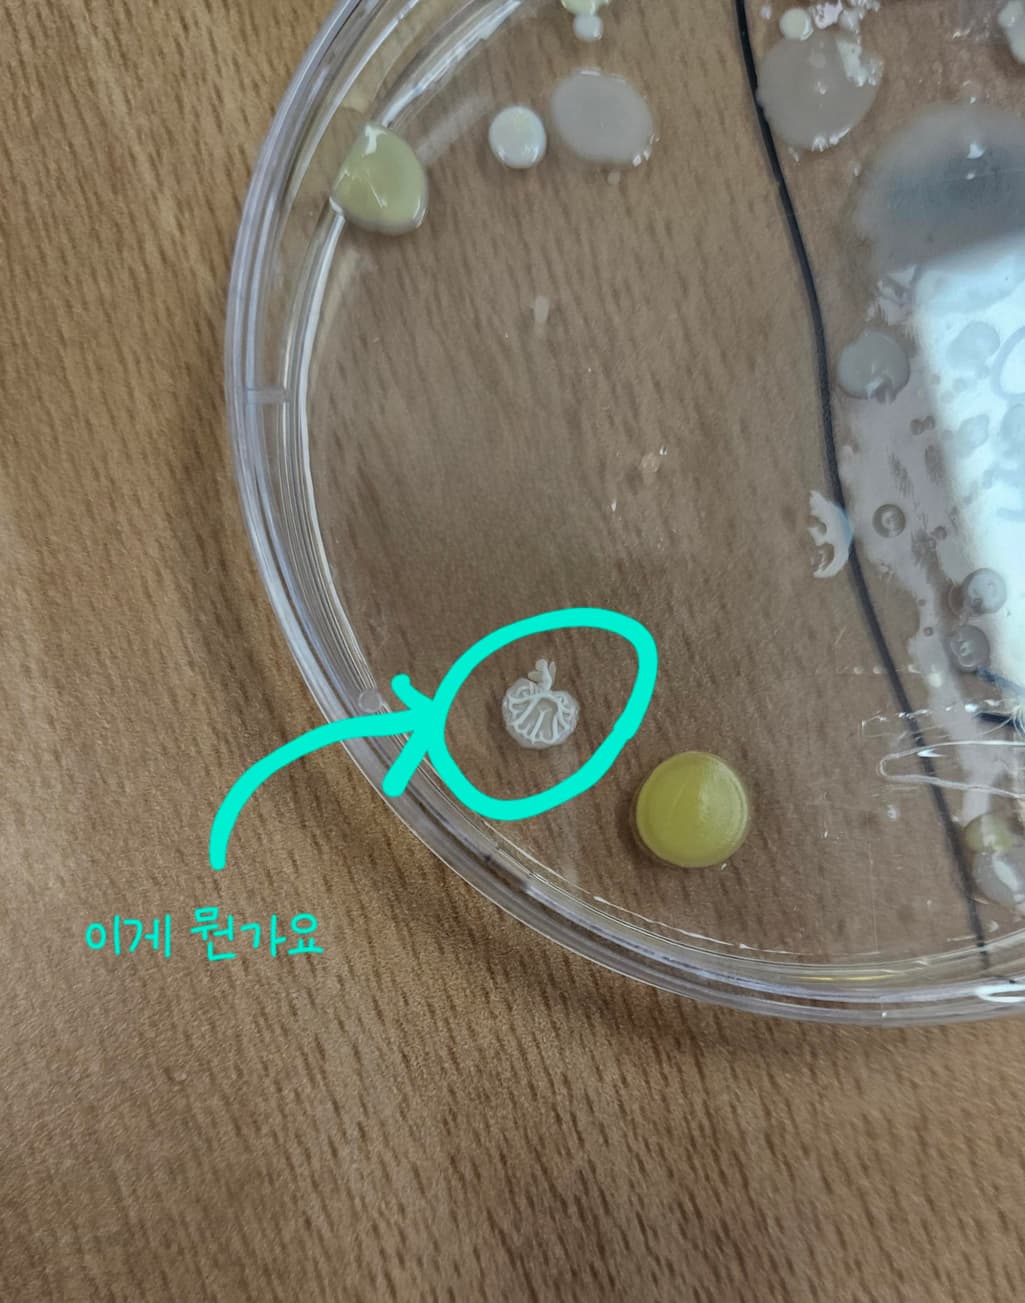
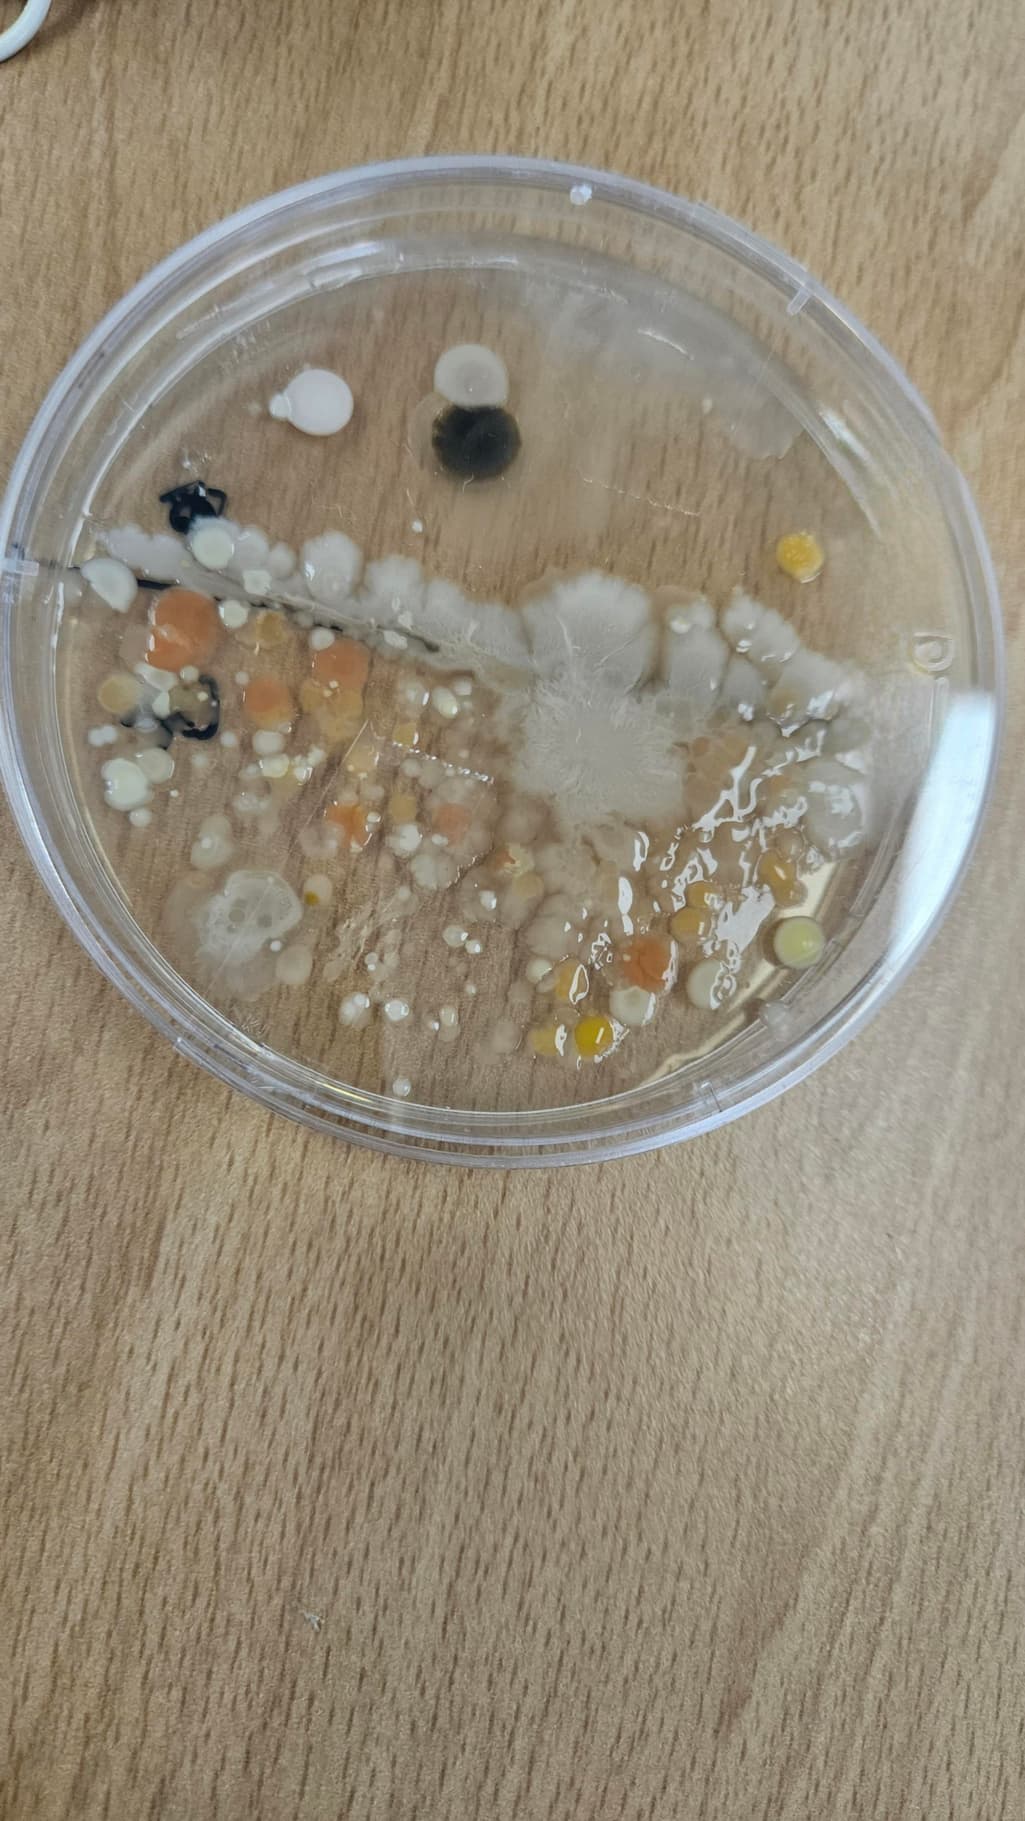

곰팡이 배양 실험의 원리가 뭔가요??
곰팡이 배양실험 원리가 알고 싶습니다. 그리고 그 실험에 들어가는 물질과 그 역할까지 세세히 알려주셨으면 좋겠습니다! 그리고 두 번째 사진에 있는 뇌모양처람 생긴 건 뭔지도 궁금합니다
안녕하세요. 김지호 박사입니다. '곰팡이'란 진핵생물 균류 중에서 진균류에 속하는 생물을 말합니다. 흔히 곰팡이 배양에는 PDA 배지를 많이 사용하는데요, PDA 배지란 Potato Dextrose Agar의 약자입니다. 이는 감자와 dextrose의 영양분과 한천의 고체화 성질을 이용하여 미생물을 배양하는 배지입니다. 이후 적정농도로 희석한 곰팡이 검체를 spreading한 후 37도에서 배양해주시면 됩니다.
안녕하세요. 황정웅 전문가입니다.
곰팡이 배양실험은 여러가지 방법이 있고 각 실험의 목적에 따라 다양한 물질이 사용됩니다.
그래서 진행하신 실험에 어떤 물질이 사용되었는지는 다 알 수 없지만,
추측해본다면 곰팡이의 영양분이 되는 성분이 들어있는 한천 배지를 만들어 곰팡이를 접종해 배양한 것으로 보입니다.
곰팡이만 배양하기 위해서 세균을 제거하는 항생제를 첨가하기도 합니다.
곰팡이의 포자가 일상의 여러곳에 있기 때문에 배지를 손으로 건드리는 것 만으로 여러가지 곰팡이를 배양할 수 있습니다.
동그라미 쳐주신 부분은 곰팡이의 균사체로 추측됩니다.
안녕하세요.
곰팡이 배양 실험은 곰팡이의 생장을 위한 최적의 환경을 제공하여, 그 생장을 관찰하고 특정 조건에서의 반응을 평가하는 것이 주 목적입니다. 두번째 사진에 있는 뇌 모양의 구조는 아마도 곰팡이의 콜로니일 가능성이 높습니다. 이 구조는 특정 종류의 곰팡이가 배양되면서 형성한 집합체로 곰팡이가 분비하는 효소와 대사 산물에 의해 다양한 형태와 색상을 나타낼 수 있습니다.
장도연이 추천하는 아하!
앱으로 편리하게 사용해 보세요.
장도연이 추천하는 아하!
앱으로 편리하게 사용해 보세요.